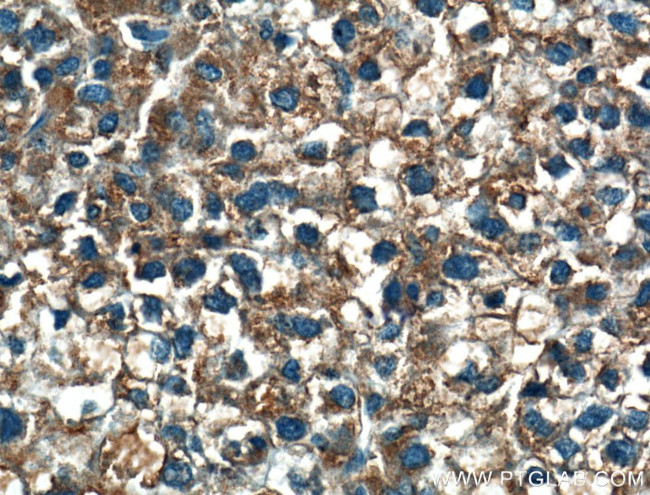
MOSC2 Antibody in Immunohistochemistry (Paraffin) (IHC (P))

Search
Proteintech
MOSC2 Polyclonal Antibody
{{$productOrderCtrl.translations['antibody.pdp.commerceCard.promotion.promotions']}}
{{$productOrderCtrl.translations['antibody.pdp.commerceCard.promotion.viewpromo']}}
{{$productOrderCtrl.translations['antibody.pdp.commerceCard.promotion.promocode']}}: {{promo.promoCode}} {{promo.promoTitle}} {{promo.promoDescription}}. {{$productOrderCtrl.translations['antibody.pdp.commerceCard.promotion.learnmore']}}
产品信息
24782-1-AP
种属反应
宿主/亚型
分类
类型
抗原
偶联物
形式
浓度
规格
纯化类型
保存液
内含物
保存条件
运输条件
产品详细信息
Immunogen sequence: YENNCLIFR APDMDQLVLP SKQPSSNKLH NCRIFGLDIK GRDCGNEAAK WFTNFLKTEA YRLVQFETNM KGRTSRKLLP TLDQNFQVAY PDYCPLLIMT DASLVDLNTR MEK (118-229 aa encoded by BC011973)
靶标信息
As a component of the benzamidoxime prodrug-converting complex required to reduce N-hydroxylated prodrugs, such as benzamidoxime. Also able to reduce N(omega)-hydroxy-L-arginine (NOHA) and N(omega)-hydroxy-N(delta)-methyl-L-arginine (NHAM) into L-arginine and N(delta)-methyl-L-arginine, respectively.
仅用于科研。不用于诊断过程。未经明确授权不得转售。
生物信息学
蛋白别名: mARC2; Mitochondrial amidoxime reducing component 2; moco sulfurase C-terminal domain-containing protein 2; MOCO sulphurase C-terminal domain containing 2; Molybdenum cofactor sulfurase C-terminal domain-containing protein 2; MOSC domain-containing protein 2; MOSC domain-containing protein 2, mitochondrial; RP11-270A6.1; unnamed protein product
基因别名: 2810484M10Rik; mARC1; MARC2; Mg87; MOSC2; MTARC2
UniProt ID: (Human) Q969Z3, (Mouse) Q922Q1
Entrez Gene ID: (Human) 54996, (Mouse) 67247